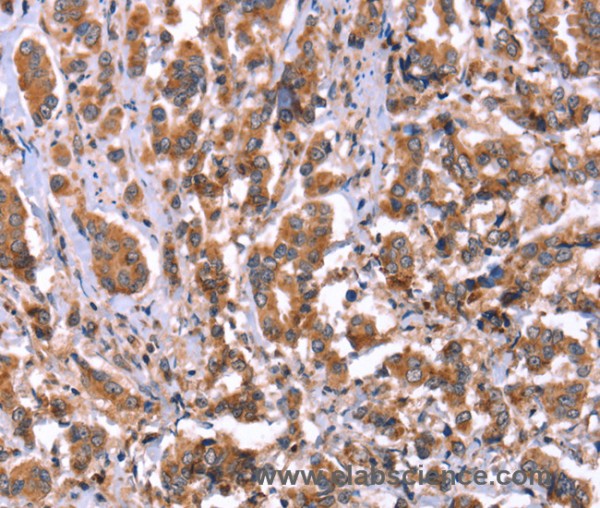
Anti-HRG

Cookie preferences
This website uses cookies, which are necessary for the technical operation of the website and are always set. Other cookies, which increase the comfort when using this website, are used for direct advertising or to facilitate interaction with other websites and social networks, are only set with your consent.
Configuration
Technically required
These cookies are necessary for the basic functions of the shop.
"Allow all cookies" cookie
"Decline all cookies" cookie
CSRF token
Cookie preferences
Currency change
Customer-specific caching
FACT-Finder tracking
Individual prices
Selected shop
Session
Comfort functions
These cookies are used to make the shopping experience even more appealing, for example for the recognition of the visitor.
Note
Show the facebook fanpage in the right blod sidebar
Statistics & Tracking
Affiliate program
Conversion and usertracking via Google Tag Manager
Track device being used
If you have any questions, please use our Contact Form.
You can also order by e-mail: info@biomol.com
Larger quantity required? Request bulk
You can also order by e-mail: info@biomol.com
Larger quantity required? Request bulk
This histidine-rich glycoprotein contains two cystatin-like domains and is located in plasma and... more
Product information "Anti-HRG"
This histidine-rich glycoprotein contains two cystatin-like domains and is located in plasma and platelets. The physiological function has not been determined but it is known that the protein binds heme, dyes and divalent metal ions. It can inhibit rosette formation and interacts with heparin, thrombospondin and plasminogen. Two of the protein's effects, the inhibition of fibrinolysis and the reduction of inhibition of coagulation, indicate a potential prothrombotic effect. Mutations in this gene lead to thrombophilia due to abnormal histidine-rich glycoprotein levels. Protein function: Plasma glycoprotein that binds a number of ligands such as heme, heparin, heparan sulfate, thrombospondin, plasminogen, and divalent metal ions. Binds heparin and heparin/glycosaminoglycans in a zinc-dependent manner. Binds heparan sulfate on the surface of liver, lung, kidney and heart endothelial cells. Binds to N-sulfated polysaccharide chains on the surface of liver endothelial cells. Inhibits rosette formation. Acts as an adapter protein and is implicated in regulating many processes such as immune complex and pathogen clearance, cell chemotaxis, cell adhesion, angiogenesis, coagulation and fibrinolysis. Mediates clearance of necrotic cells through enhancing the phagocytosis of necrotic cells in a heparan sulfate-dependent pathway. This process can be regulated by the presence of certain HRG ligands such as heparin and zinc ions. Binds to IgG subclasses of immunoglobins containing kappa and lambda light chains with different affinities regulating their clearance and inhibiting the formation of insoluble immune complexes. Tethers plasminogen to the cell surface. Binds T-cells and alters the cell morphology. Modulates angiogenesis by blocking the CD6-mediated antiangiongenic effect of thrombospondins, THBS1 and THBS2. Acts as a regulator of the vascular endothelial growth factor (VEGF) signaling pathway, inhibits endothelial cell motility by reducing VEGF-induced complex formation between PXN/paxillin and ILK/integrin-linked protein kinase and by promoting inhibition of VEGF-induced tyrosine phosphorylation of focal adhesion kinases and alpha-actinins in endothelial cells. Also plays a role in the regulation of tumor angiogenesis and tumor immune surveillance. Normalizes tumor vessels and promotes antitumor immunity by polarizing tumor-associated macrophages, leading to decreased tumor growth and metastasis. [The UniProt Consortium]
| Keywords: | Anti-HRG, Anti-HPRG, Anti-Histidine-rich glycoprotein, Anti-Histidine-proline-rich glycoprotein, HRG Polyclonal Antibody |
| Supplier: | Elabscience |
| Supplier-Nr: | E-AB-13302 |
Properties
| Application: | IHC, ELISA |
| Antibody Type: | Polyclonal |
| Conjugate: | No |
| Host: | Rabbit |
| Species reactivity: | human |
| Immunogen: | Synthetic peptide of human HRG |
| Format: | Purified |
Database Information
| KEGG ID : | K23410 | Matching products |
| UniProt ID : | P04196 | Matching products |
| Gene ID : | GeneID 3273 | Matching products |
Handling & Safety
| Storage: | -20°C |
| Shipping: | 4°C (International: -20°C) |
Caution
Our products are for laboratory research use only: Not for administration to humans!
Our products are for laboratory research use only: Not for administration to humans!
Information about the product reference will follow.
more
You will get a certificate here
Viewed